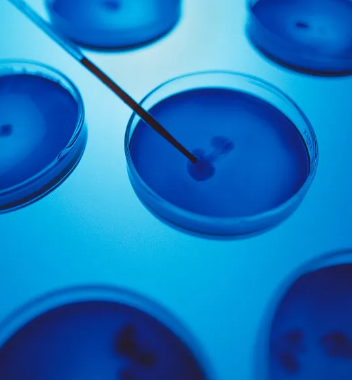
image.png

臍帶血幹細胞價格,國内幹細胞價格參考
2024-09-03 14:29:12 來源: 小編 咨詢醫生
臍帶血幹細胞是一種具有高度分化潛能的細胞,主要用于治療血液病、免疫系統疾病及其他一些疾病。随着醫療技術的進步,臍帶血幹細胞的應用範圍逐漸擴大,其市場需求也随之增加。在國内,臍帶血幹細胞的存儲和治療服務的價格受多種因素影響,下面我們就來探讨臍帶血幹細胞的價格及其影響因素。
1.臍帶血幹細胞的存儲價格
在國内,臍帶血的存儲通常由專業的臍帶血銀行提供服務。存儲費用主要包含一次性的采集費和每年的存儲費。根據市場調查,臍帶血的存儲費用一般在1萬元至3萬元之間,具體價格取決于以下幾個因素:
技術水平:不同臍帶血銀行的技術力量和設備條件不同,價格也會有差異。一些知名的臍帶血銀行可能因技術較爲先進,收費較高。
服務内容:一些臍帶血銀行會提供更全面的服務,例如定期健康檢查、幹細胞挽救計劃等,這些附加服務也會影響最終的存儲費用。
2.臍帶血幹細胞的提取費用
臍帶血的提取費用一般包含在存儲費用中,但如果考慮到單獨提取,價格也在數千元至萬元不等。提取費用的高低主要與以下因素有關:
醫院資質:一些知名醫院的臍帶血提取服務可能價格相對較高,但提供的醫療保障和服務也更爲可靠。
市場競争:随着越來越多的醫療機構和臍帶血銀行進入市場,價格也可能随之波動。當地的供需關系也會對費用産生影響。
3.幹細胞治療的費用
除了存儲費用,臍帶血幹細胞在臨床上的應用(如疾病治療)也需要相應的費用。根據不同的疾病類型和治療方案,幹細胞治療的費用差異較大,可能從幾萬元到幾十萬元不等。這些費用通常包括:
前期評估:患者接受幹細胞治療前需要進行全面的健康評估,所需的檢查和評估費用也需計入。
治療過程:治療過程中的藥物、手術和護理等費用是主要的開銷。
術後随訪:治療後的觀察和随訪也需持續支付一定的費用。
4.影響價格的其他因素
除了上述費用項目,臍帶血幹細胞的價格還可能受到**法規、市場需求和科研進展等多方面的影響。政府的相關**或**措施可能會影響幹細胞市場的價格波動。此外,科研的進展和新技術的應用也可能降低或提升幹細胞存儲和治療的整體費用。
結論
總的來說,臍帶血幹細胞的價格因地區、銀行、服務内容等因素的不同而有所差異。在選擇臍帶血存儲或治療服務時,家長們應多方對比,選擇适合自己的機構及服務。此外,關注相關法律法規及市場趨勢,将有助于做出更爲明智的決策。
文章來源:https://www.2008eshop.cn/ganxibao/37344.html
- 2024-10-20醫院打幹細胞一針多少錢?性價比分析。
- 2024-11-27幹細胞移植醫療費用如何,移植過程安全嗎
- 2024-11-02台州人體幹細胞治療價格高嗎?幹細胞價格影響因素有哪些?
- 2024-11-22幹細胞治療脊髓病變費用多少,治療周期大概多長
- 2024-08-30幹細胞治療不孕不育有效果嗎多少錢
- 2024-11-18骨髓造血幹細胞移植費用多少,安全性和效果如何保證
- 2024-10-11幹細胞抗衰老真的靠譜嗎?哪些人群适合做?
- 2024-09-23幹細胞局部移植費用多少,收費明細一覽
- 2024-10-10幹細胞及基因編輯技術哪家強?前沿研究揭秘
- 2024-09-10幹細胞技術應用到眼角膜移植時,優勢在哪裏
- 2024-08-07幹細胞療法治療肝硬化,幹細胞治療肝硬化有效果嗎
- 2024-09-18幹細胞注射後美容效果附注意事項
- 2024-08-08幹細胞填充效果好嗎,幹細胞填充面部能維持多長時間
- 2024-09-18自體幹細胞的制備過程是怎麽樣的
- 2024-09-26幹細胞存儲公司招聘,任職要求是什麽
- 2024-10-11幹細胞治療鼻炎真的有效嗎?有沒有臨床數據支持?
- 2024-09-20打幹細胞抗衰老有副作用嗎
- 2024-09-17儲存幹細胞的生物機構有哪些,幹細胞儲存權威機構
